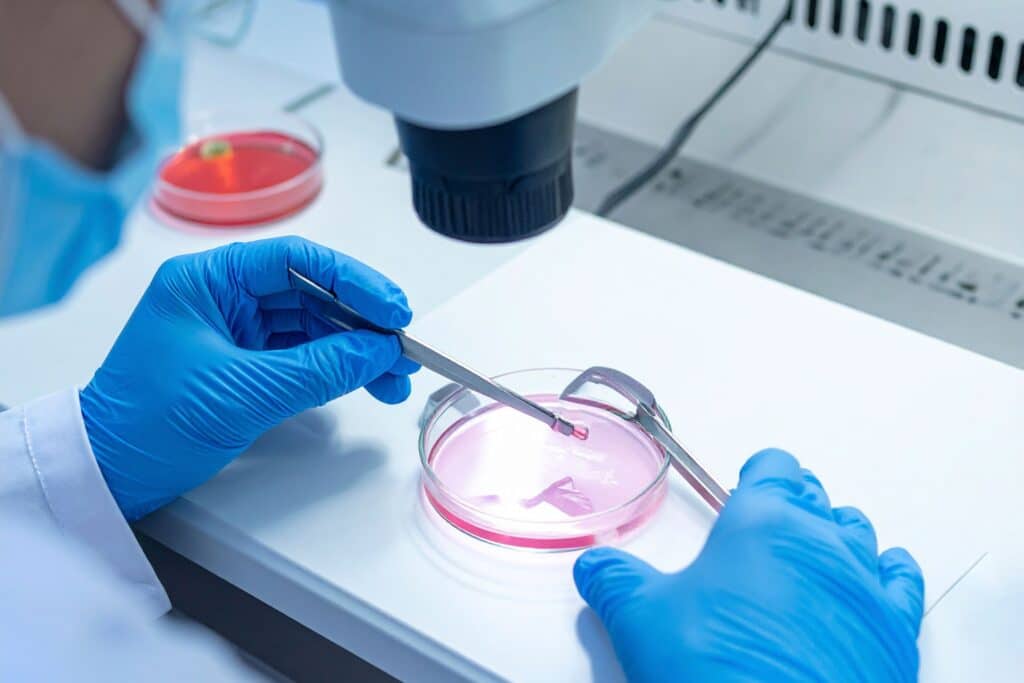

Articles
-

NDP MP Proposes New Crime of Downplaying Residential Schools
November 26, 2025Criminal hate speech laws are increasingly a topic of discussion in the House of… Read More
-

New Bill to Increase Penalties for Mischief Against Religious Property
November 25, 2025Across Canada, but especially in large multicultural cities, 2025 has seen a troubling rise… Read More
-

Health Canada Releases Report on Advance Requests for Euthanasia
November 13, 2025“Charlie is told that he has Alzheimer’s disease. His doctor sits down with him… Read More
-

Alberta Citizens’ Initiative on Independent School Funding
November 12, 2025An effort is underway to remove public funding for independent schools in Alberta. It’s… Read More
-

Government Leaves Religious and Pro-Life Organizations Alone in 2025 Budget
November 6, 2025Pro-life Christians can breathe a sigh of relief. Actually, you can take two. The… Read More
-

Motion from MLA Janet Routledge is an opportunity for important discussion on abortion
October 22, 2025October 21 For Immediate Release Abortion impacts many people in the province and an… Read More
-

ARPA Condemned in the BC Legislature
October 8, 2025On October 6th, for almost an hour, British Columbia MLAs debated the “views and… Read More
-

Quebec Moves to Outlaw Prayer in Public Spaces
October 8, 2025Why is Quebec Banning Public Prayer? The Quebec government has announced plans to ban… Read More
-

Abortion and Mental Health
October 2, 2025Do women who choose to have an abortion live just as happy and healthy… Read More
-

New Hate Speech Legislation in Canada
September 25, 2025In 2024, the Trudeau government introduced the Online Harms Act (Bill C-63) to combat… Read More
-

What is a parent? God’s good design for the family
September 17, 2025Despite Ontario’s and British Columbia’s efforts to redefine parenthood, the biblical design for the… Read More
-

What is a Parent? British Columbia Proposes to Further Redefine the Term
September 15, 2025What is a parent? In recent decades, society has been asking questions whose answers… Read More
-
More Babies, More Questions: The Ethical Crisis Behind Assisted Reproduction
September 10, 2025In their 2024 annual report, the Canadian Fertility and Andrology Society released its Canadian… Read More
-

Press Release: Niagara Pride and St. Catharines Mayor Pressure Private Advertiser to Remove Child-Protection Billboards
September 6, 2025FOR IMMEDIATE RELEASESeptember 6, 2025 ST. CATHARINES, ON – A series of billboards urging… Read More
-

Mahmoud v Taylor
August 11, 2025The American Supreme Court continues to be busy. After upholding the legality of an… Read More
-

UN Report Stands Up for Women and Girls
August 7, 2025Sex-based violence against women and girls – violence perpetrated against females solely because they… Read More
-

Supreme Court Upholds Canada’s Prostitution Law, for now
July 30, 2025Last week, Canada’s Supreme Court unanimously upheld Canada’s criminal prohibitions on procuring persons for… Read More
-

Glimmers of Hope in Public Opinion on Pride
July 23, 2025What are Canadian values? In recent months we’ve heard a lot of talk about… Read More
-

Twenty Years of Same-Sex Marriage in Canada
July 21, 2025July 20, 2025, marks the 20th anniversary of the legalization of same-sex marriage in… Read More
-

U.S. Supreme Court Upholds Age-Verification
July 14, 2025Kids in Canada can easily access internet pornography – often without even meaning to. … Read More
-

Alberta Public School Library Book Consultation Results
July 3, 2025A little over a month ago, the Alberta government initiated a public survey to… Read More
-

Protecting minors online: Bill C-216 seeks to improve safety for youth in the digital age
June 27, 2025Pornography continues to be a public health crisis in Canada, especially for minors. As… Read More
-

“Parental Transparency and Age-Appropriate Education Act” Introduced in British Columbia
June 26, 2025The following was an exchange in the BC legislature a little less than two… Read More
-

Bill C-218 Proposes to Scrap Expansion of Euthanasia for Mental Illness
June 20, 2025MP Tamara Jansen introduced a new bill that would repeal the expansion of euthanasia… Read More
-

Tax Fairness for Families
June 19, 2025With summer here, many families are looking forward to summer holidays and many politicians… Read More
-

Age-Verification Bill Reintroduced in the Senate
June 17, 2025Across much of the western world, governments are beginning to recognize the harmful effects… Read More
-

Press Release: ARPA Canada Challenges London’s “Graphic Image” Bylaw as Unconstitutional Restriction on Pro-Life Expression
June 11, 2025The Association for Reformed Political Action (ARPA) Canada has initiated litigation against the City… Read More
-

Manitoba Proposes Official Celebration of Pride
June 3, 2025Four provinces – British Columbia, Alberta, Manitoba, and Ontario – dedicate certain days, weeks,… Read More
-

Life in the Negative World
May 29, 2025If you pay any attention to public affairs in Canada, you already know that… Read More
-

Can a Child Have More Than Two Parents?
May 26, 2025Imagine a lesbian couple and a sperm donor choosing to raise a child together… Read More
-

What Should Canadian Christians Think About King Charles Reading the Throne Speech?
May 21, 2025On May 27, King Charles will read the Canadian government’s speech from the throne…. Read More
-

Book Review: The Body God Gives
May 19, 2025Theology used to be considered “queen of the sciences.” Universities recognized that God’s Word… Read More
-

What is Justice?
May 16, 2025This article was written by former ARPA Intern, Lucas Wuthrich According to the Merriam-Webster… Read More
-

UK settles meaning of “woman” in equality law – now how about Canada?
May 12, 2025The UK Supreme Court recently ruled, in For Women Scotland, that “sex” and “woman”… Read More
-

Alberta Updates Education Act
May 8, 2025Alberta is updating its Education Act again. And just like the last update, which… Read More
-

BC Nurse Disciplined for Speaking Out on Gender Identity
May 7, 2025Amy Hamm is a registered nurse in B.C. and a J.K. Rowling fan. But… Read More
-

Ontario’s top court rules against COVID-era outdoor gatherings ban
April 15, 2025Randy Hillier, a former Progressive Conservative and then independent MPP, was a prominent critic… Read More
-

Quebec Doubles Down on Secularism. Is the Rest of Canada Next?
April 10, 2025“God keep our land glorious and free” ~ Canadian national anthem “Whereas Canada is… Read More
-

The Problem of Online Gambling and Its Promotion
April 9, 2025Last fall, Maclean’s published a story about Phil, a young man addicted to gambling…. Read More
-

Gambling: Value or Vice?
April 7, 2025Is gambling harmless recreation or a destructive vice? If the latter, can government do… Read More
-

Alberta Introduces Bill on Online Gambling
April 4, 2025At the end of March, Minister of Service Alberta and Red Tape Reduction Dale… Read More
-

Expelled for Pro-Life Beliefs? The Ongoing Legal Battle of Rafael Zaki
April 2, 2025In 2019, a Coptic Christian named Rafael Zaki was expelled from medical school at… Read More

